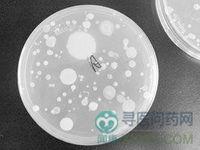

气痢有实证和虚证之分。实证的基本征候特征为为粪便如蟹沫稠粘,有里急后重感,腹胀,大便时排气多,其气臭秽。或兼肠鸣、小便不利等。是由于湿热郁滞,气机不得宣畅所致。虚证的基本征候特征为为腹胀排气时大便即随之而下,是由于中气下陷,肠虚不固所致。
就诊科室:中医科 中医综合易感人群:无特定人群需做检查:粪便上皮细胞 粪便隐血试验(OBT) 粪细菌培养 尿常规 血常规 便常规 肠镜常用药物:枯草杆菌二联活菌颗粒 口服轮状病毒活疫苗 蒙脱石散剂 复方地芬诺酯片 泻痢固肠丸 双歧杆菌三联活菌胶囊 酪酸梭菌活菌胶囊 蒙脱石散 金锁昆都尔片 五味黄连丸 枯草杆菌二联活菌肠溶胶囊 鞣酸蛋白酵母散 复合乳酸菌胶囊 四味脾胃舒片 乳酸菌素颗粒 肉蔻四神丸 健儿药丸 温脾固肠散 复方嗜酸乳杆菌片 苋菜黄连素胶囊 复方谷氨酰胺肠溶胶囊 双岐杆菌四联活菌片 小儿复方磺胺甲噁唑散 洁白丸 盐酸洛哌丁胺胶囊 复方仙鹤草肠炎片 四神丸 凝结芽孢杆菌活菌片 小儿腹泻宁合剂 肚痛健胃整肠丸典型症状:肠鸣 大便粘腻 腹胀 里急后重 排气多传染方式:无传染性治疗方式:无传染性相关疾病:腹胀 白痢 暴痢 赤痢 噤口痢 气臌 气胀 湿热痢 休息痢 疫毒痢